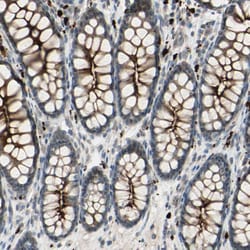
Invitrogen LMTK2 Polyclonal Antibody 100 &mu;L; Unconjugated:Antibodies,

missing translation for 'onlineSavingsMsg'
Learn More
Learn More
Invitrogen™ LMTK2 Polyclonal Antibody
Rabbit Polyclonal Antibody
Brand: Invitrogen™ PA582402
This item is not returnable.
View return policy
Description
Immunogen sequence: MELNGVQADF KPATLSSSLD NPKESVITGH FEKEKPRKIF DSEPLCLSDN LMHQDNFDPL NVQELSENFL FLQEKNLLKG SLSSKEHIND LQTELKNAGF TEAMLETSCR NSLDTELQFA ENKPGLSLLQ ENV Highest antigen sequence indentity to the following orthologs: Mouse - 66%, Rat - 59%.
Protein kinases are enzymes that transfer a phosphate group from a phosphate donor, generally the g phosphate of ATP, onto an acceptor amino acid in a substrate protein. By this basic mechanism, protein kinases mediate most of the signal transduction in eukaryotic cells, regulating cellular metabolism, transcription, cell cycle progression, cytoskeletal rearrangement and cell movement, apoptosis, and differentiation. With more than 500 gene products, the protein kinase family is one of the largest families of proteins in eukaryotes. The family has been classified in 8 major groups based on sequence comparison of their tyrosine (PTK) or serine/threonine (STK) kinase catalytic domains. The tyrosine kinase (TK) group is mainly involved in the regulation of cell-cell interactions such as differentiation, adhesion, motility and death. There are currently about 90 TK genes sequenced, 58 are of receptor protein TK (e.g. EGFR, EPH, FGFR, PDGFR, TRK, and VEGFR families), and 32 of cytosolic TK (e.g. ABL, FAK, JAK, and SRC families).
Specifications
| LMTK2 | |
| Polyclonal | |
| Unconjugated | |
| LMTK2 | |
| 2900041G10Rik; A330101P12Rik; aatyk2; Apoptosis-associated tyrosine kinase 2; brain-enriched kinase; BREK; CDK5/p35-regulated kinase; cprk; cyclin-dependent kinase 5/p35-regulated kinase; FLJ46659; hBREK; Kiaa1079; kinase phosphatase inhibitor 2; kinase/phosphatase/inhibitor 2; KPI2; KPI-2; KPI-2 protein; Lemur tyrosine kinase 2; LMKT2; LMR2; Lmtk2; PPP1R100; protein phosphatase 1, regulatory subunit 100; serine/threonine-protein kinase KPI-2; Serine/threonine-protein kinase LMTK2 | |
| Rabbit | |
| Antigen affinity chromatography | |
| RUO | |
| 22853 | |
| Store at 4°C short term. For long term storage, store at -20°C, avoiding freeze/thaw cycles. | |
| Liquid |
| Immunohistochemistry (Paraffin), Immunocytochemistry | |
| 0.1 mg/mL | |
| PBS with 40% glycerol and 0.02% sodium azide; pH 7.2 | |
| Q8IWU2 | |
| LMTK2 | |
| Recombinant protein corresponding to Human LMTK2. Recombinant protein control fragment (Product #RP-89805). | |
| 100 μL | |
| Primary | |
| Human | |
| Antibody | |
| IgG |
Product Content Correction
Your input is important to us. Please complete this form to provide feedback related to the content on this product.
Product Title
Spot an opportunity for improvement?Share a Content Correction